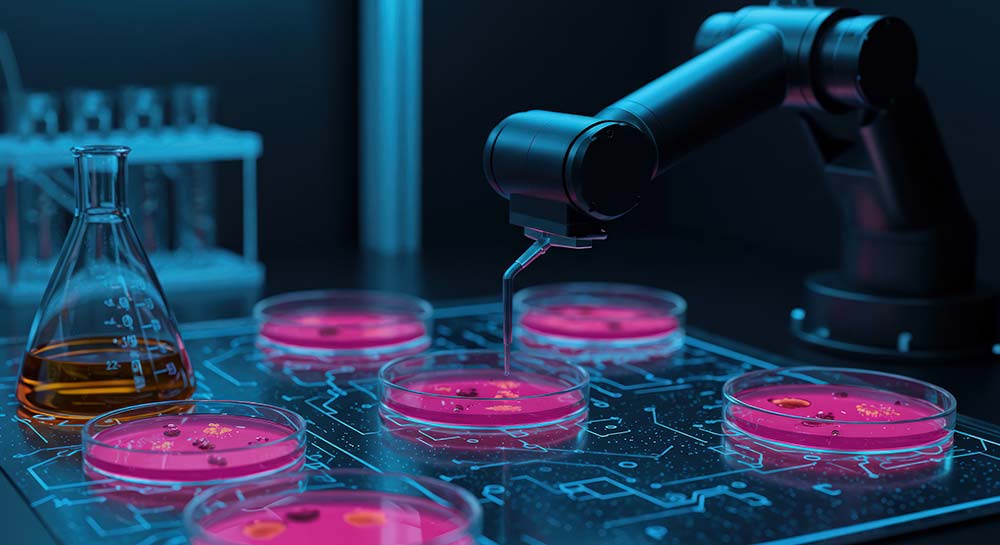

科学公报
华熙生物PDRN创新技术突破
——引领行业从“随机”迈向“精准”新时代
2025年11月10日 09:21
近日,华熙生物的一项关于“特定序列核酸分子及其作为PDRN的应用”的发明专利(申请号:202511375770.9;公开号:CN120859873A)正式通过国家知识产权局公开。该专利发明创造性地突破了传统动物源PDRN技术瓶颈,获得了多条确证和序列和功效的PDRN分子,为化妆品和医药行业提供了一种新的护肤、修复功效成分。该发明专利以“序列可控、安全无毒、功效更强”三大核心优势,为化妆品高端修护赛道与医用伤口愈合领域带来革命性解决方案,标志着华熙生物在生物活性修复成分研发领域取得又一关键性突破。
华熙依托合成生物学研发平台,基于AI辅助序列高通量筛选与功效研究的创新方案,在60000+基因组基因序列库中筛选到了序列确定、分子量可控及功效可验证的多条PDRN序列,不具有细胞毒性,安全性高,能有效促进血管内皮生长因子VEGF表达的,有效修复细胞受损,在功能性护肤品、医疗器械领域拥有巨大的市场前景。
三大核心创新:从“随机分子”到“精准序列”,重新定义PDRN技术标准
从基因层面锁定功能性序列,这意味着PDRN不再是随机片段的混合物,而是具有明确碱基排列的精准分子,分子量100%可控,使得每一批次产品的活性成分均可追溯、可调控。同时,功效实验结果显示,该技术下制备的PDRN促进血管内皮生长因子(VEGF)表达的能力显著优于传统鲑鱼提取的PDRN,可加速受损皮肤细胞的修复周期。
序列信息100%来源于鲑鱼基因组,GC含量与人体GC含量的相似度达100%,制备工艺无需依赖动物提取,符合全球监管与消费者趋势,消除动物来源在医疗与化妆品领域的应用壁垒。
该技术制备的PDRN产品有效成分含量稳定,生产工艺全链路可控,结合发酵技术的无限扩产能力,可实现质量可控、低碳环保的产业可持续发展化目标。
此前,华熙生物已布局动物提取,微生物发酵来源的PDRN,该产品是继以上两代PDRN技术后,第三代纯合成生物技术实现的与人体基因组GC含量的相似度达100%,无需依赖动物提取,且序列可控、纯度更高的颠覆性技术产品。该项目为华熙生物利用合成生物学方法在全球范围内首次获得与人体基因组100%相似的PDRN精准序列库,可实现分子量与产品质量的精准把控。同时,华熙生物已完成“序列与功效”关联关系的理论体系及产品体系构建,将推动行业从“随机提取”向“精准研发”转型升级,助力行业标准化与高质量发展,进一步拓展生物活性成分应用边界。
Bioπ中国美肤科学传播平台发布本文只是为了更多的信息参考,不代表任何有倾向性的投资意见或市场暗示。
THE END
指导单位:中国香料香精化妆品工业协会
受托运营:中国香妆融媒体
京ICP备2025131973号